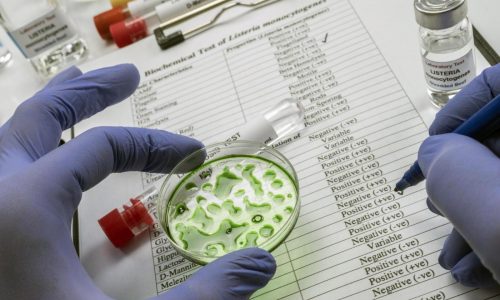
Boar’s Head among cheese brands in listeria recall from Walmart, Target, others

Depleted Bruins fall to Rangers, 6-2
With all the absences from their lineup, the Bruins needed to play about a perfect game to come out on top of the New York...
Boar’s Head among cheese brands in listeria recall from Walmart, Target, others
By David J. Neal, Miami Herald Grated cheese sold under four brands has been recalled at various stores nationwide, including Walmart, Sam’s Clubs and Target,...
Boar’s Head among cheese brands in listeria recall from Walmart, Target, others
By David J. Neal, Miami Herald Grated cheese sold under four brands has been recalled at various stores nationwide, including Walmart, Sam’s Clubs and Target,...
Patriots defensive starter praised after stepping up for top special-teamer
FOXBORO — It was an all-hands-on-deck game for Patriots special teams coordinator Jeremy Springer in last week’s win over the Bengals. Springer has to find...
Dos buques petroleros se incendian en el mar Negro tras ser atacados, dicen autoridades turcas
Por SUZAN FRASER y ANDREW WILKS ANKARA, Turquía (AP) — Dos petroleros fueron atacados y se incendiaron en el mar Negro, lo que provocó el...
Bodycam footage from Operation Midway Blitz released: ‘It’s all about arresting people’
Footage from nearly four dozen body cameras worn by immigration agents during Operation Midway Blitz was released to the public on Wednesday, capturing in shaky,...